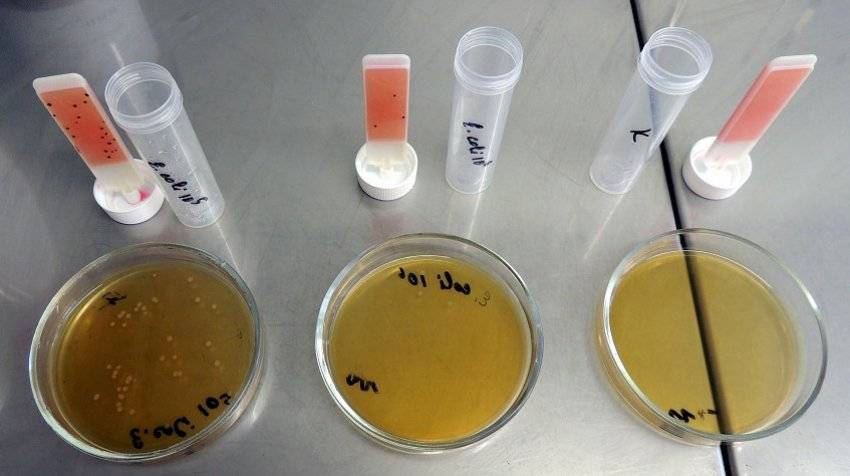

Как собирают гнездо пчел на зиму: общие сведения
С чего обычно начинают свою осеннюю подготовку пчел к зимовке? Первым делом, пасечник производит осмотр пчелиных семей и расчет их силы. Стоит помнить, что осенью сила пчелиной семьи имеет склонность стремительно уменьшаться. Пасечник убирает лишние соты, в которых не содержатся засева, и начинается сборка гнезда пчел на зиму. Произведя расчет, сколько необходимо в улье оставить рамок, лишние изымаются, а с рамки кормом выставляются так, чтобы леток улья был расположен по центру пчелиного гнездаВсе рамки гнезда, что попали под сокращение, подвергаются сортировке: сушь, рамки с кормами и выбраковка. Первые две категории необходимо правильно хранить в особых помещениях (сотохранилищах). Выбракованные соты сушат, скрывают и возвращают в улей за заставную доску. Сборку гнезда пчел на зиму стараются провести как можно раньше, чтобы насекомые подготовились: сформировали ложе и перенесли в гнездо часть кормов из остывших выбракованных рамок.
В основном остаются пчелы в зиму в лежаках. По разным причинам пчеловоды используют разные варианты сборки гнезд. Как правило, на выбор влияет сила семьи и тип улья. Ознакомимся с ними:
- Способ для тех семей, где очень мало засева. На края гнезда устанавливают полностью запечатанные рамки с медом. Середина гнезда отводится для рамок запечатанных только наполовину. Помимо них в середину ставят парочку маломедных рамок. Бывает, что в улье находится всего одна рамка с засевом. В этом случае ее ставят в центре гнезда.
- Второй способ применяется в семьях, где осталось много рамок с засевом. Тут очередность установки рамок иная: полностью запечатанные рамки ставятся на один край гнезда, печатные наполовину – следом за ними, после идут маломедные и завершается это все полностью печатной рамкой.
- Способ «бородка» довольно противоречивый и используется пчеловодами при недостаточном пополнении кормов на зимовку. Все используемые соты, предназначенные для гнезда на зиму, полностью запечатаны. В них для создания пчелами ложа распечатывают только небольшую полоску шириной 5-7 см. В центр гнезда пасечник устанавливает рамки с печатным медом, а по краю – маломедные рамки.

Наращивание численности пчел осенью
Подготовка пчелиных семей к зимовке — тоже очень важный этап. Значительная часть успешной зимовки зависит от численности рабочих пчел в семье. Они должны в холода согревать клуб, а весной первыми совершить облет и предоставить первый взяток. Для этого нужны исключительно молодые пчелы, родившиеся в конце августа и в течение сентября.
Сначала следует провести ревизию семейств. Если у какой-то из сильных семей нет ни ячеек, ни расплода, то нужно выявить наличие маточной пчелы. В конце сезона численность пчел сокращается, поэтому следует уменьшить количество гнезд. Сначала удаляют соты с небольшими объемами меда, а такие же соты, но с расплодом размещают на край гнезд, чтобы матка не смогла использовать их под новый расплод. Чтобы насекомые свободно могли транспортировать мед из дальних рамок в гнездо, нужно их определить за диафрагму улья по одной.
Чтобы пополнить численность семьи, пчеловоды прибегают к искусственному созданию условий. В гнезде располагают 2 или 3 не полностью занятые сотами рамки с хорошими ячейками. Рекомендуют, чтобы соты были светло-коричневого цвета. Такой окрас стимулирует матку на размножение, и она должна активнее откладывать яйца.
Для стимуляции жителей улья нужно их подкармливать жидким сахарным сиропом. Таким образом создается имитация лета, и пчелы ведут себя активнее и готовы к уходу за расплодом и выкармливанию молодняка.
Важно, чтобы пополнение семей молодняком было своевременным. В противном случае молодые особи не успеют облетаться, и к весне в улье будет много плохо перезимовавших пчел, они просто погибнут в зимнее время. Для осеннего приплода целесообразно использовать нуклеусы со старыми матками, которых пасечники удаляют летом из гнезд, чтобы не состоялось неподходящее роение
Изолированные королевы за этот период уже успели отложить яйца и вырастить потомство на 2-3 рамках. Их можно расположить в улей, в котором требуется увеличение семейства перед зимовкой
Для осеннего приплода целесообразно использовать нуклеусы со старыми матками, которых пасечники удаляют летом из гнезд, чтобы не состоялось неподходящее роение. Изолированные королевы за этот период уже успели отложить яйца и вырастить потомство на 2-3 рамках. Их можно расположить в улей, в котором требуется увеличение семейства перед зимовкой.
Кроме того, у каждого пасечника должны быть нуклеусы с запасными королевами, чтобы в случае утери одной из маток ее можно было бы сразу заменить.
Важно следить за заменой старых истощенных королев. Только молодые, крепкие и здоровые матки способны откладывать хорошее количество молодняка и таким образом успеть пополнить семьи перед холодами
Подготовка семей к зимовке
Необходимо нарастить массу молодых, здоровых, невыработанных работниц. Старые особи для зимовки пчёл не нужны: всё равно до весны не доживут. Только мёд зря используют на свое содержание.
- Рассчитываем время, до которого матка должна откладывать яйца. От даты последнего облёта в вашей местности отнимаем месяц. Чтобы свежевыведенные пчёлы успели облетется перед зимовкой.
- До этого времени стимулируем яйцекладку побудительной подкормкой (при отсутствии взятка). При содержании пасеки ежегодно или через год сменяем маток: молодые червят дольше.
- Проводим лечебные мероприятия. Дважды обрабатываем от варроатоза, которым, увы, сейчас заражены все пасеки. Первый раз – по окончании главного взятка: без снижения количества паразитов нельзя вырастить полноценных работниц. Второй раз – после выхода всего расплода: при его отсутствии эффективность любой обработки максимальна, весь клещ в гнезде. Если пасека заражена другими болезнями, лечим. Перед формированием клуба хорошо дать лечебную подкормку для профилактики нозематоза. Хорошая зимовка пчёл невозможна, если у нас – больные, высосанные клещом насекомые!
- Работами по переработке сахарного сиропа, осушке и исправлению поврежденных рамок стараемся загружать старых работниц. Для этого весь скармливаемый сироп даем большими дозами сразу после главного взятка.
- Если выдался хороший день для облёта, а насекомые уже в клубе, можно попытаться стуком, шумом, частичным разбором гнезда побудить их к вылету. Чем позже облетятся, тем меньше каловая нагрузка на зимовке пчёл.
Выделяем запасных маток в маленькие семьи. Обычно хватает времени сформировать нуклеусы после главного взятка на зрелый маточник. Матки облетятся и успеют нарастить достаточно молодых особей для хорошей зимовки пчёл. Такие семейки получаются недорогими по себестоимости: и рабочих особей, и маточников в это время, при минимальных усилиях пчеловода, хватает. Содержание 10% запасных маток от количества семей пасеки позволяет спасти от гибели потерявшую матку. Или в следующем сезоне развить в полноценную единицу, как на видео.
Подготовку к зимовке начинаем сразу после главного взятка, одновременно с отбором мёда. Уже тогда, перебирая рамки, оставляем расплодные и маломёдные коричневые (их матки предпочитаю весной), формируем нуклеусы для запасных маток, очищаем фальцы, готовим и раздаём сахарный сироп. Проводим лечебные мероприятия.
Как правильно подготовить рамки?
Отбирая соты на холодный период, необходимо обратить внимание на то, что все ячейки должны быть покрыты восковой пленкой и запечатаны – это способствует сохранности меда. Для закладки на зимовку лучше всего отбирать рамки со светло-коричневатым оттенком сот
Большинство специалистов считают, что матка, когда начинает расплод, охотнее откладывает яйца в ячейки такого цвета, т. к. он наиболее привлекателен для нее
Для закладки на зимовку лучше всего отбирать рамки со светло-коричневатым оттенком сот. Большинство специалистов считают, что матка, когда начинает расплод, охотнее откладывает яйца в ячейки такого цвета, т. к. он наиболее привлекателен для нее.
Продукт в таких сотах быстро густеет и засахаривается, становясь неудобоваримым. Такие темные соты являются благоприятной средой для развития различных вирусов и бактерий, которые провоцируют болезни в улье.

Применение в медицине
- Рапсовый мед используют для лечения заболеваний печени, он чистить желчевыводящие протоки.
- Полезен для слизистой оболочки носа, горла.
- Этот сорт меда – лучшее спазмолитическое лекарственное средства, обладает отхаркивающим эффектом. Рекомендуют использовать при лечении кашля, польза видна уже через несколько дней.
- С помощью пчелиного рапсового продукта можно снять воспаление со слизистой оболочки горла. Для этого нужно столовую ложку меда добавить в стакан молока. Также, это одно из лучших профилактических лекарственных средств для лечения горла, с помощью его можно укрепить иммунную систему, имеет полезные свойства.
Пчелиный продукт давно используют народные целители, он имеет регенеративную функцию, с помощью его можно восстановить клетки, заживить обширные ожоги, язвы, омолодить кожу. Пчелиный продукт полезен, потому что в нем содержится сахароза, декстрин, глюкоза, это питательный продукт. Описание продукта народными знахарями, целителями доказывает его ценность. Редко может нанести вред, только тогда, когда не учитываются противопоказания .

Отличается рапсовый мед от других сортов тем, что не является сильно сладким, его рекомендуют использовать при лечении кишечника, желудка. Во время беременности нужно с утра съесть пол столовой ложки меда, так можно защититься от токсикоза.
Продукт быстро усваивается, насыщает организм важными полезными элементами. Рекомендуют употреблять для укрепления сердечных мышц. Если человек постоянно подвергается усиленным физическим нагрузкам, его нужно обязательно включить в свой рацион рапсовый мед
Когда глюкоза оказывается в сосудах, она поступает в головной мозг, у человека восстанавливаются все когнитивные процессы – память, мышление, внимание. Описание нектара говорит о том, что его необходимо ежедневно есть, когда человек занимается интеллектуальной деятельностью, польза доказана
Часто рапсовый мед используют в косметологии, с него можно приготовить освежающую маску, скраб. Свойства рапсового меда доказаны.
Правильно пересаживаем пчел
Пасечнику следует осуществлять замену улья быстро, чтобы не погубить насекомых и их расплод, выводимый по весне, не допустить покидания роем нового жилища. Пчеловоду понадобится дымарь, переносной ящик и инструменты.
Жилище пчелосемьи сдвигают, закрыв предварительно летки. На подставку водружают пустой чистый корпус. В него переносят поочередно хорошие рамки из старого улья, обсиженные пчелами, добавляют при необходимости корм.
Ползающим особям понадобится установка доски, листа фанеры между летками. Осыпавшихся с рамок пчел нужно собрать на лопатку и стряхнуть внутрь нового жилья.
Вся процедура не должна занимать более 15 минут, иначе семейство переохладится.
О температуре воздуха
Важно подобрать подходящий день для пересадки пчел. Ее можно осуществить ранней весной при температуре воздуха не ниже +14-15°C утром, если стоит солнечная, безветренная погода. Холод опасен для расплода
Холод опасен для расплода.
При пересадке пчел в конце весны проще следить, чтобы на извлеченные рамки не прилетали насекомые из других домиков. Они обычно уже заняты работой по добыче взятка и не стремятся украсть мед.
Переселение в ульи другого типа
Процесс осложняется, если новый домик пчел отличается от старого более маленькими размерами, формой. Перенос семейства осуществляют не ранее конца весны. С рамок, на которых насекомые поместили расплод по весне, стряхивают взрослых пчел в новый домик. Конструкции обрезают до нужных размеров и также ставят в готовый чистый улей.
При необходимости переносят соты с медом и пергой, уменьшая их. Все излишки скармливают насекомым. Угощение сахарным сиропом позволит быстрее привыкнуть к новому жилью и укрепить гнездо к концу весны.
Рекомендации по утеплению
После пересадки пчелам нужна комфортная температура для адаптации и размножения, тем более что их гнездо до конца весны обычно уменьшается. Новый улей утепляют по бокам и сверху (над холстиком, прикрывающим рамки) тканевыми подушками с наполнителем, укрывают пленкой. Внутрь матов, подушек можно насыпать солому, мох.
Обеспечение подогрева
В период холодной ранней весны пчелам можно помочь, установив электрические обогреватели, чтобы повысить температуру гнезда. Выбирают удобное место для них по бокам улья либо под рамками. Процесс размножения при оптимальной температуре идет гораздо быстрее, если имеется достаточный запас корма.
На каком меде пчелы лучше зимуют

Соты, которые будут оставлены, предварительно осматривают. На них не должно быть меньше 2 кг продукта, ячейки должны быть хорошо запечатаны. В таком состоянии мед лучше сохраняется, не закисает и не теряет своих полезных свойств.
Сорта, которые оставляют для зимовки, могут быть разными. Не используют вересковый и падевый виды. Падевый мед собирают с листьев, он может содержать декстрины и продукты обмена белков насекомых-паразитов. Опасным для насекомых в зимнее время становится питание с примесью пади. Щелочные металлы, которые содержатся в составе, оседают на стенках кишечника пчелиных особей и приводят к губительному нарушению пищеварения.
Единственным способом избежать подобной проблемы становится полное удаление пади из улья.
Сорта, которые подвержены быстрой кристаллизации, не подходят для зимовки. Это виды, собранные с крестоцветных типов растений, а также эвкалиптовый и хлопковый. Чтобы уменьшить риски помора, необходимо:
- исключить быстрокристаллизующиеся виды;
- оставить в улье светло-коричневые соты;
- обеспечить влажность в зимовнике не менее 80 – 85 %.
Особенности зимовки пчел на подсолнечниковом меде
Подсолнечниковый – это сорт, который собирают с масличной культуры, подсолнечника. Это лидер по содержанию глюкозы. Многие пчеловоды научились использовать его в качестве корма, который оставляют на зиму. Главный недостаток продукта – быстрая кристаллизация.
При использовании подсолнечникового сорта зимой необходимо добавлять дополнительное подкармливание. Для этого подходит самостоятельно приготовленный сахарный сироп, который добавляют в ульи.
Несколько правил, которые помогут перенести зимовку пчелам на подсолнечниковом меде:
- оставлять светлые соты, это замедляет процесс кристаллизации;
- использовать подсолнечниковый мед первого отбора;
- поддерживать оптимальный уровень влажности в зимовнике.

Перезимуют ли пчелы на рапсовом меде
Сорт собирают с крестоцветного растения, рапса, которое появилось в результате селекционного скрещивания. Этот сорт отличается показателями быстрой кристаллизации.
Рапсовый мед не рекомендуют оставлять для зимовки. Пчеловоды, которые планируют разводить семьи и дорожат своей репутацией как поставщика качественного продукта, выкачивают рапсовый мед по мере цветения и оставляют для зимовки другие сорта.
Зимовка пчел с помощью рапсового меда возможна в южных регионах, но она может быть осложнена возникающими проблемами. Кристаллизация рапсового сорта отличается повышенными показателями затвердевания. Для дальнейшего существования пчелосемьи необходимо подкармливать сахарным сиропом. Использование сиропа как основного кормового материала может привести к весеннему подмору.
Как зимуют пчелы на гречишном меде
Гречишник собирают с цветков гречихи, для него характерен темно-коричневый оттенок. Он обладает полезными качествами. Гречишный мед подходит для лечения множественных заболеваний человека, но для зимовки пчел его использовать не рекомендуют. Категорически непригоден сорт гречихи для хозяйств, расположенных в Западной и Центральной Сибири. При его использовании наблюдается весенний нозематоз у пчел, в результате которого большая часть гибнет, а остальные выходят из зимовки ослабленными.
На территории Сибири гречишник откачивают из улья задолго до подготовки к зимованию пчелосемей.
В европейской части страны гречишник считают пригодным для зимовки из-за смещения сроков кристаллизации ввиду изменения температурного режима. Его оставляют для зимовки, но предусматривают дополнительный докорм самостоятельно приготовленным сахарным сиропом.
Другие разновидности меда для зимовки пчел
Пчеловодство как отрасль ведет статистический учет о качестве и количестве нектара, собранные данные облегчают процесс планирования зимовки на меде. Оптимальный вариант, который подходит для содержания семей зимой, минимизирует риск развития нозематоза и снижает показатели весеннего подмора, – это выбор цветочных сортов.

К ним относят липовый, разнотравье, донник, кипрейный, акациевый сорта. Эти виды пользуются популярностью на рынке, поэтому пчеловоды иногда экономят при расчетах количества продукта, который необходимо оставлять на зиму.
Кроме того, следует учитывать запас кормового меда, который нужно оставлять в улье пчелам на зиму в случае нехватки. Он должен храниться отдельно от помещения для зимовки и составлять примерно 2 – 2,6 кг для одной семьи.
Правила и методы отбора качественного мёда для зимовки пчёл
Для отбора качественного мёда следует провести ряд анализов, которые покажут наличие в мёде пади. Это сладкая жидкость, которую выделяют насекомые, которые питаются соком растений. В отличие от нектара, падевый мёд не содержит фитонцидов и других полезных веществ. У пчёл, питающихся падью, продолжительность жизни может снижаться более чем вдвое.

Уксусно-свинцовый способ
Для проведения анализа данным способом используется специальная походная лаборатория Темнова.
Предметы, которые понадобятся для лаборатории:
- чемодан для пробирок;
- стеклянная чаша;
- компаратор;
- флакон с водой;
- кристаллический уксуснокислый свинец;
- дистиллированная вода;
- большая пипетка для воды;
- маленькая пипетка для реактивов.
Знаете ли вы? Продолжительность жизни рабочей пчелы составляет не более 40 дней.
Пошаговая инструкция метода:
- В небольшую пробирку набрать мёд, приблизительно 1/5 часть, и залить водой.
- Перелить всё содержимое в большую пробирку.
- В маленькую пробирку вновь налить воды, стараясь смыть остатки мёда с неё. Перелить всё в большую.
- В раствор добавить 2 капли уксуснокислого свинца.
- Тщательно перемешать.
- Поставить пробирку в компаратор и сквозь него посмотреть, как через очки, на линию горизонта.
- Рядом стоит контрольная пробирка с цветочным мёдом. Если через первую пробирку не видно линии горизонта, то пади слишком много.
- Чтобы лучше определить проверяемый пчелиный мёд на количество пади, в него по капле добавлять воду до того момента, пока прозрачность не сравняется с контрольной пробиркой.
- Если при добавлении воды количество капель — больше 60, то мёд некачественный и его лучше не использовать для подкормки.

Спиртовой анализ
Смешать мёд и дистиллированную воду в соотношении 1:1. Далее нужно взять 10 частей винного спирта и всё тщательно перемешать между собой. Если начинают появляться мутные вкрапления, то в мёде содержится падь.
Важно! Спиртовой анализ не подходит для гречишного мёда, так как он сам по себе даёт помутнение
Известковый анализ
Смешать 1 часть мёда и 1 часть дождевой воды, если её нет, то можно использовать дистиллированную. Также к смеси добавить 2 части известковой воды, которую можно приготовить самостоятельно — для этого надо 100 г негашеной извести залить 1 л холодной воды, тщательно перемешать и процедить через марлю.
Далее подготовленную смесь нагреть до кипения и рассмотреть: если есть хлопья, которые выпали в осадок, — это говорит о том, что в продукте присутствует падь.
Узнайте, как содержать пчёл в погребе зимой.
Для подготовки пчёл к зимовке необходимо не только заготовить нужное количество мёда для питания насекомых, но и проверить его качество. А регулярный уход за ульями поможет пчелиным семьям без проблем пережить зиму и в следующем сезоне приступить к своей привычной работе.
Описание
К сожалению, многие пчеловоды-пасечники и по сей день не горят желанием выставлять пчелиные домики возле безграничных полей, укрытых желтым покрывалом цветов, дающих головокружительный сладкий аромат. Дело в том, что они ошибочно относят рапсовый продукт пчеловодства к низкосортному и такому, что не найдет своего потребителя.А вот опытные пчеловоды считают, что, по большому счету, не имеет значения, носят пчелы нектар из лесных опушек или с хозяйственных полей. Главное, чтобы мед получался вкусным.
Так кто прав, а чье мнение ошибочное. Давайте подробнее рассмотрим все достоинства и недостатки рапса и меда из него:
- рапс относится к капустному семейству, из-за чего существенного вреда никому не приносит;
- его широко культивируют, как следствие, цветущие поля рапса действительно безграничны;
- из ярко-желтых цветов (период цветения с конца весны до начала лета) пчелы за сутки могут собрать не менее 8 кг ароматного нектара.
- к тому же рапс на полях цветет и в конце лета и начале осени, что дает поздний взяток.
Как видим, растение во всех отношениях полезное. Естественно, что нектар из рапса обязательно превратится в мед и станет характеризоваться:
- общим ярко-желтым цветом с небольшими вкраплениями беловатого оттенка;
- особым ароматом, имеющим терпкий приторно-сладкий привкус;
- очень густой структурой (часто мед кристаллизуется, еще будучи в сотах, что для пчел плохо, поэтому пчеловоды избегают ставить ульи возле рапсовых полей);
- «засахариванием» через 3 недели, что, в принципе, на полезные свойства никак не влияет;
- легкой горчинкой после устаивания и мелкозернистой структурой белого цвета;
- неприятным свойством быстрого скисания, из-за чего его хранение должно быть под постоянным контролем и только в стеклянной таре, это большой минус;
- плохим растворением в воде.
Но так как рапсовые поля действительно «реки медовые», то для товарного производства большие пасеки размещают около рапса. Поэтому стоит отметить тот факт, что практически все европейские супермаркеты заполняют «медовые полки» именно этим рапсовым медовым продуктом, давая ему названия майский, весенний или пионерский мед. А вот пчелам такой нектар принесет только вред, потому довольно быстро кристаллизуется мед даже в ульях. И ни в коем случае нельзя допускать попадания рапсового меда в рамки для зимовки, пчелосемьи погибнут. Вот поэтому пчеловоды не любят, когда поблизости о пасеки цветет осенью рапс, так как когда гнезда уже собраны на зиму и попадание рапсового нектара в рамки принесет только вред во время зимовки пчел.
Правила подготовки корма
Для того, чтобы не волноваться всю зиму за насекомых, пасечнику до зимы необходимо накопить или купить качественный ингредиент. Сорт не имеет совершенно никакого значения, но падевый и вересковый сорта не рекомендуется запасать на время зимы.
Пчёлы вырабатывают падевый в том случае, если не удалось получить нектар, который им необходим в достаточном количестве. Поэтому вместо нектара пчёлы питаются соками, которые выделяют из себя деревья. Для человека данный сорт полностью безопасен, но пчёлы могут погибнуть от долгого его употребления. Губит в основном их остаток белкового обмена. От остатков белкового обмена в продукте почти нельзя избавиться.
Вересковый не имеет в своём составе опасных веществ, но чрез время он начинает загущаться, поэтому насекомым становится всё труднее употреблять его в пищу.
Рекомендуется использовать наиболее свежий продукт, поскольку его кристаллизация происходит чуть медленнее. Также в проветриваемых помещениях или на улице, где много ветра, кристаллизация происходит чуть быстрее обычного. Также запасы корма для этого вида насекомых не только кристаллизуются, но и закисают. Чтобы предотвратить это, необходимо урегулировать температурный режим. Температура воздуха не должна превышать двенадцать градусов Цельсия.
Когда качать мед в зоне умеренного климата
Выкачка меда медогонкой
Если ваш регион расположен в средней полосе страны, то вполне разумным считается вопрос, когда начинают качать мед в средней полосе. Конечно, период во многом зависит от погодных условий. Чем раньше зацветут весенние растения, тем быстрей произведется откачка. Как правило, это конец месяца июня, но в некоторых случаях выкачка выпадает и на середину июля. Первый сбор дает обычно небольшой урожай, но зато последний приятно вас удивит. Когда собирают вторично? В период цветения липы, но не позже конца августа, так как осенью пчелы уже начинают готовиться к зимовке.
Советы опытных пчеловодов
Чтобы повысить урожайность своей пасеки, необходимо прислушаться к следующим советам опытных пчеловодов:
На свободном земельном участке подсевать медоносы
Отлично работает донник, клевер или расторопша.
Помимо наличия кормовой базы, важно исключить присутствие на растениях пестицидов. Поэтому, нельзя использовать такие препараты, как на своем участке, так и стараться избегать их появления у соседей
Если это исключить невозможно, желательно вывозить пасеку на определенный промежуток времени на другую территорию, которая будет являться экологически более благоприятной и дружелюбной по отношению к насекомым.
Важно в улей вносить свободные рамки вовремя. Таким образом расширяется пространство для наращивания количества собранного меда.
Важно следить в обязательном порядке со здоровьем пчелиной семьи. При первых признаках появления болезни, вирусной или грибковой инфекции, а также паразитов, принимать срочные меры по их устранению. Причем, необходимо изолировать этот домик, в котором появились признаки болезни от других, чтобы не допустить заражения всей пластики.
Еще лучше – проводить профилактические мероприятия.
Всегда помнить, что насекомые должны зимовать комфортно. Для этого утепляют домики и пополняют кормовые запасы, обеспечивая не только мед, но не пергу.
Сборка пчелиных ульев на зиму
Подготовка пчел к зимовке начинается еще во время основного медосбора, то есть в июле. Именно в это время насекомые производят самый качественный и питательный мед. Рамы, подготовленные для зимовки, нужно устанавливать во второй декаде сентября, так как в этот период пчелы перестают делать запасы.
Разделяют 2 вида сборки ульев.
- Односторонняя, когда соты размещаются в следующем порядке: 1 рамка на 3,5 кг, далее — на 1,5 кг, 3 рамки на 2 кг, затем 1 – на 2,5 кг. В завершение устанавливают 2 рамки на 3 кг.
- Двусторонняя, при которой в середине улья ставят 2 рамки на 2 кг корма, далее с каждой стороны еще по одной рамке на 2 кг, затем на 3 кг.
Когда нужно начинать подготовку
Формировать гнездо нужно тогда, когда расплода будет совсем мало и большая часть молодняка уже выведется. Вот тогда и можно начинать подготовку пчел к зимнему периоду. Практически все старые пчелы к этому моменту погибнут, и по количеству молодняка можно будет определить силу пчелиной семьи. Пасечнику нужно заранее позаботиться о том, чтобы после сборки насекомым до холодов хватило времени для подготовки и упаковки гнезда. Сборка выполняется так, чтобы леток располагался по центру гнезда.
Как правильно подготовить рамки
Для заготовки рамок подходят соты светло-коричневого оттенка, а вот рамы с темными сотами использовать нельзя. В этих ячейках содержится обычно слишком много зародышевых кристаллов, оказывающих пагубное влияние на новый урожай. Мед загустевает и быстрее кристаллизуется. Кроме того, в таких сотах чаше развиваются болезнетворные микроорганизмы, провоцирующие различные пчелиные болезни.
Ячейки во всех рамах должны быть в запечатанном виде. Так мед длительное время будет оставаться свежим. Восковая крышечка не дает влаге и воздуху проникнуть внутрь ячейки. А в незапечатанных сотах мед начинает закисать и становится жидким. Если улей находится в тепле, мед нередко кристаллизуется.
Уход за пчелами в зимний период
Пчелы зимой не нуждаются в особом уходе. Чтобы насекомые комфортно себя чувствовали, нужны всего лишь три условия.
- Оптимальная температура. Известно, что насекомым вредят и жара, и сильный холод.
- Свет. Вход в зимовник пасечник должен обустроить таким образом, чтобы не было яркого освещения. Лучше всего подойдет фонарь с красной лампой. Он светит приглушенно, к тому же пчелы не различают красный цвет.
- Приемлемый уровень шума. Зимой насекомые особо чувствительны к внешнему раздражителю. При повышенном шуме они будут вылетать наружу, где неизбежно погибнут от холода.
Если одна из семей по какой-то причине стала беспокойной, придется срочно принимать меры, чтобы не растревожить остальных пчел. Один из способов — снизить температуру в зимовнике, ненадолго открыв двери. Лучше всего сделать это ночью или поздним вечером, чтобы не допустить попадания солнечных лучей.
























































